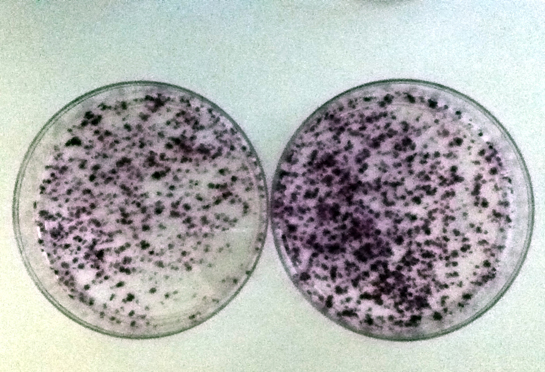

Investigadores del grupo de Medicina Molecular de la Universidad de Castilla-La Mancha (UCLM) y de la Universidad de Valencia analizan por primera vez cómo aparecen y se acumulan las mutaciones en el genoma del virus de la hepatitis C. Según el artículo, publicado en la revista Nature Microbiology, «la tasa de mutación varía de forma muy diversa a lo largo de todo el genoma con variaciones extremas incluso entre nucleótidos adyacentes».
La revista Nature Microbiology ha publicado recientemente los resultados de una investigación llevada a cabo por un grupo de expertos, entre los que se encuentra el grupo de Medicina Molecular de la Universidad de Castilla-La Mancha (UCLM), que demuestran cómo el virus de la hepatitis C presenta una alta tasa de mutación. Además, se han detectado diferencias de más de mil veces entre unos sitios del genoma y otros.
Las mutaciones espontáneas, explican en la investigación, son la última fuente de variación genética y tienen un papel destacado en la evolución. Los virus con RNA (Ácido ribonucleico) como material genético, como el virus de la hepatitis C (HCV), “muestran una tasa de mutación extremadamente alta, aunque hasta ahora se había deducido a partir de una pequeña fracción de los sitios del genoma, limitando nuestra visión de cómo los virus RNA crean diversidad”,-indican los investigadores.
Este grupo de expertos ha descubierto ahora, mediante la aplicación de técnicas de secuenciación masiva a un sistema de replicón viral, cómo se distribuyen las mutaciones a lo largo del genoma viral y qué tipo de mutaciones predominan. Los resultados muestran diferencias de más de mil veces en la mutabilidad entre diferentes sitios del genoma, y se han podido identificar como principales factores de esta variedad: la composición de bases, la presencia de agrupaciones con tasas de mutación alta o baja y el sesgo entre transiciones y transversiones.
“Además, nos encontramos con que la mutabilidad se correlaciona con la capacidad que tiene el virus de la hepatitis C de variar en pacientes”,-señalan, mientras afirman que estos datos proporcionan un excelente punto de partida para analizar la selección natural, la carga genética, y la capacidad de evolución en este virus, “todo ello íntimamente relacionado con el fenotipo de resistencia a los fármacos antivirales y con la evasión a la respuesta inmune”.
En este trabajo ha participado el grupo de Medicina Molecular, perteneciente al Centro Regional de Investigaciones Biomédicas (CRIB) de la Universidad de Castilla-La Mancha e investigadores del Instituto Cavanilles de Biodiversidad y Biología Evolutiva de la Universidad de Valencia. La investigación ha sido financiada a través del proyecto VIRMUT del European Research Council.